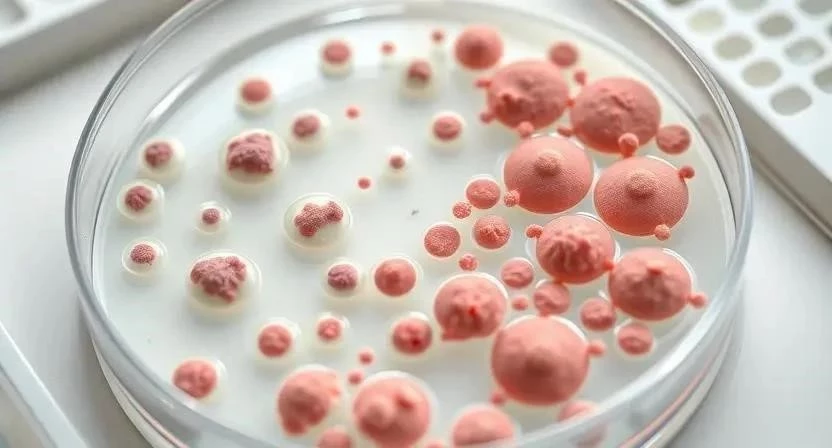

Задумывались ли вы, насколько быстро бактерии адаптируются к современным антибиотикам? Бактериальные инфекции остаются одной из главных угроз для здоровья населения во всем мире. По данным Всемирной организации здравоохранения, устойчивость к антибиотикам – это одна из десяти основных угроз для глобальной безопасности здравоохранения. В этой статье мы рассмотрим современные методы лечения, новые препараты и стратегии борьбы с этой серьезной проблемой.
- Что такое бактериальные инфекции
- Современные методы диагностики
- Новые антибиотики и препараты
- Использование искусственного интеллекта
- Альтернативные методы лечения
- Профилактика бактериальных инфекций
- Перспективы развития
- FAQ
- Список новых антибиотиков и их характеристики
- Факторы риска развития бактериальных инфекций
- Методы профилактики бактериальных инфекций
Что такое бактериальные инфекции
Бактериальные инфекции вызываются патогенными микроорганизмами – бактериями. Существует огромное разнообразие бактерий, некоторые из которых безвредны и даже полезны для организма, в то время как другие могут вызывать серьезные заболевания. Пути заражения бактериями разнообразны: через воздух, воду, пищу, контакт с зараженными поверхностями или людьми. Факторы риска развития бактериальных инфекций включают ослабленный иммунитет, хронические заболевания, несоблюдение правил гигиены и нерациональное использование антибиотиков.
Современные методы диагностики
Своевременная и точная диагностика – ключевой фактор успешного лечения бактериальных инфекций. Лабораторные исследования, такие как бактериологический посев, позволяют идентифицировать возбудителя и определить его чувствительность к антибиотикам. Метод ПЦР (полимеразной цепной реакции) позволяет быстро и точно обнаружить ДНК бактерий в биологическом материале. Определение чувствительности к антибиотикам (антибиотикограмма) помогает выбрать наиболее эффективный препарат для лечения конкретной инфекции.

Новые антибиотики и препараты
Разработка новых антибиотиков – сложный и дорогостоящий процесс, но он необходим для борьбы с растущей устойчивостью бактерий. Фтортиазинон – новый антибиотик, обладающий широким спектром действия против грамотрицательных бактерий. Цефтолозан/тазобактам – комбинация цефалоспорина и ингибитора бета-лактамаз, эффективная против устойчивых штаммов. Цефтазидим/авибактам – еще одна комбинация, используемая для лечения сложных инфекций, вызванных грамотрицательными бактериями. Крезомицин и Orlynvah – относительно новые препараты, демонстрирующие перспективные результаты в клинических испытаниях.
Использование искусственного интеллекта
Искусственный интеллект (ИИ) открывает новые возможности в борьбе с бактериальными инфекциями. Нейросети могут быть использованы для поиска новых молекул, обладающих антибактериальной активностью. ИИ также может помочь в диагностике инфекций, анализируя медицинские изображения и данные пациентов. Например, алгоритмы машинного обучения могут выявлять признаки инфекции на рентгеновских снимках или в анализах крови с высокой точностью.
Устойчивость к антибиотикам – серьезная проблема, требующая комплексного подхода. Рациональное использование антибиотиков – ключевой фактор в борьбе с устойчивостью. Антибиотики следует принимать только по назначению врача и строго соблюдать дозировку и продолжительность лечения. Профилактика распространения инфекций, включая соблюдение правил гигиены и вакцинацию, также играет важную роль. Разработка новых стратегий, таких как использование бактериофагов и иммунотерапии, может помочь преодолеть устойчивость бактерий.
Альтернативные методы лечения
Бактериофаги – вирусы, которые заражают и уничтожают бактерии. Их использование в качестве альтернативного метода лечения бактериальных инфекций набирает популярность. Иммунотерапия – метод лечения, направленный на усиление иммунного ответа организма на инфекцию. Пробиотики – живые микроорганизмы, которые могут улучшить микрофлору кишечника и повысить иммунитет.
Профилактика бактериальных инфекций
Профилактика – лучший способ избежать бактериальных инфекций. Соблюдение правил гигиены, таких как регулярное мытье рук, помогает предотвратить распространение бактерий. Вакцинация – эффективный способ защиты от многих бактериальных инфекций. Здоровый образ жизни, включающий правильное питание, достаточный сон и физическую активность, укрепляет иммунитет и снижает риск заражения.
Перспективы развития
В настоящее время проводятся активные исследования по разработке новых антибиотиков и альтернативных методов лечения бактериальных инфекций. Правительство РФ разрабатывает планы по поддержке отечественных производителей антибиотиков и развитию научных исследований в этой области. Ожидается, что новые технологии, такие как геномное редактирование и нанотехнологии, также внесут вклад в борьбу с бактериальными инфекциями.
FAQ
Вопрос: Что такое антибиотикограмма?
Ответ: Антибиотикограмма – это исследование, которое определяет чувствительность бактерий к различным антибиотикам.
Вопрос: Как правильно принимать антибиотики?
Ответ: Антибиотики следует принимать только по назначению врача, строго соблюдая дозировку и продолжительность лечения.
Вопрос: Что такое бактериофаги?
Ответ: Бактериофаги – это вирусы, которые заражают и уничтожают бактерии.
Вопрос: Как укрепить иммунитет?
Ответ: Здоровый образ жизни, правильное питание, достаточный сон и физическая активность помогают укрепить иммунитет.
Вопрос: Какие меры профилактики бактериальных инфекций существуют?
Ответ: Соблюдение правил гигиены, вакцинация и здоровый образ жизни – основные меры профилактики бактериальных инфекций.
Список новых антибиотиков и их характеристики
| Название | Спектр действия | Применение |
|---|---|---|
| Фтортиазинон | Грамотрицательные бактерии | Инфекции дыхательных путей, мочевыводящих путей |
| Цефтолозан/тазобактам | Устойчивые грамотрицательные бактерии | Сложные внутрибольничные инфекции |
| Цефтазидим/авибактам | Устойчивые грамотрицательные бактерии | Инфекции мочевыводящих путей, пневмония |
| Крезомицин | Широкий спектр | Различные бактериальные инфекции |
| Orlynvah | Устойчивые грамотрицательные бактерии | Инфекции мочевыводящих путей |
Факторы риска развития бактериальных инфекций
| Фактор риска | Описание |
|---|---|
| Ослабленный иммунитет | ВИЧ-инфекция, онкологические заболевания, прием иммуносупрессоров |
| Хронические заболевания | Диабет, заболевания почек, заболевания легких |
| Несоблюдение правил гигиены | Недостаточное мытье рук, контакт с зараженными поверхностями |
| Нерациональное использование антибиотиков | Самолечение, несоблюдение дозировки и продолжительности лечения |
| Госпитализация | Повышенный риск заражения устойчивыми бактериями |
Методы профилактики бактериальных инфекций
| Метод профилактики | Описание |
|---|---|
| Соблюдение правил гигиены | Регулярное мытье рук с мылом |
| Вакцинация | Защита от многих бактериальных инфекций |
| Здоровый образ жизни | Правильное питание, достаточный сон, физическая активность |
| Рациональное использование антибиотиков | Прием только по назначению врача |
| Изоляция больных | Предотвращение распространения инфекции |
